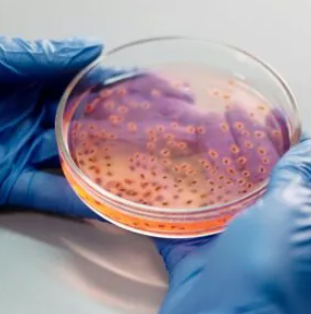

KCI Biotech supports research programs by offering specialized solutions in infectious disease studies. As an infectious diseases CRO, they help drug developers evaluate new therapies by providing controlled, science-based models and validated research workflows. These services guide early decisions in drug development and allow research teams to understand pathogen activity before clinical stages. Their work targets pharmaceutical R&D groups that need dependable preclinical direction when working with viruses, bacteria, and other pathogens. As an infectious disease CRO services provider, they contribute scientific clarity rather than consumer-focused medical care, which fits the needs of professional researchers.
Infectious Disease CRO Services Explained
As an infectious diseases CRO, they assist clients in building study designs, selecting animal models, and confirming data reliability. These infectious disease CRO services include pathogen characterization, virulence testing, and therapeutic response tracking. Instead of offering generalized advice, they support targeted workflows tailored to infectious challenges such as respiratory viruses, multidrug-resistant bacteria, or fungal complications. They also help evaluate the pharmacodynamics and safety of new compounds, ensuring research teams receive measurable and traceable results. Their experience benefits drug developers seeking reliable, repeatable data rather than one-time testing.
Platform Strengths and Research Relevance
Their infectious diseases CRO platform includes pathogenic microorganism research options that help users study growth patterns, drug action, and immune response. These infectious disease CRO services are organized to produce thorough datasets that can support regulatory submissions or guide project decisions. By offering structured pathogen testing and validated laboratory workflows, they help R&D organizations avoid unnecessary project risks. Their pathogenic microorganism services platform provides organized resources for viral or bacterial investigations, integrating microbiology, imaging, and molecular analysis into a single research environment. This approach supports scientific progress without exaggerated claims.
Conclusion
In summary, an infectious diseases CRO provides preclinical support to researchers developing anti-infective drugs. Through structured infectious disease CRO services, they help users design studies, run controlled experiments, and interpret pathogen-related outcomes. KCI Biotech offers these capabilities through an established pathogenic microorganism services platform, allowing drug developers to explore mechanisms and refine product concepts with scientific confidence. This professional structure gives R&D teams knowledge that strengthens project planning and promotes informed decision-making across infectious disease research.